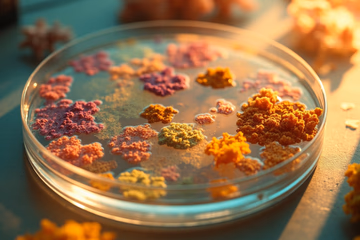
Petri dish containing bacterial colonies, representing food microbiology testing for safety and compliance.

Food microbiology testing is a key part of keeping food safe and preventing contamination. By using thorough testing methods, businesses can protect their brand reputation and safeguard public health. This testing helps to find and control harmful microorganisms that could cause foodborne illnesses, making sure that the food we eat is safe .
Effective food microbiology testing is more than just following rules; it's about a commitment to quality and safety. Using advanced techniques and strict quality control, companies such as fossanalytics.com can accurately detect and address potential risks. This helps to maintain consumer trust and avoid costly recalls .
Key Takeaways
- Food microbiology testing is crucial for preventing foodborne illnesses, complying with regulations, protecting brand reputation, and maintaining product quality.
- Various testing methods exist, including culture-based methods, PCR, ELISA, and rapid tests, each with its own advantages and disadvantages.
- Culture-based methods are traditional and can detect viable microorganisms, while PCR offers rapid and sensitive detection of specific DNA sequences.
- ELISA uses antibodies to detect specific antigens and provides rapid results, while rapid tests offer quick on-site testing but may be less accurate.
- Choosing a reliable testing partner ensures accurate results, fast turnaround times, expert guidance, comprehensive services, and compliance with industry standards.
- Accurate and reliable results are crucial for making informed decisions about food safety, production processes, and regulatory compliance.
- Investing in reliable food microbiology testing services is essential for ensuring a safer food supply and protecting public health.
Table of Contents
Introduction to Food Microbiology Testing

Food safety is paramount. The health of consumers and the reputation of brands depend on it. Food microbiology testing plays a vital role in safeguarding the food supply by identifying and controlling harmful microorganisms .
Food microbiology testing involves analyzing food products for the presence of microorganisms such as bacteria, viruses, and fungi . These microorganisms can cause food spoilage and foodborne illnesses, posing significant risks to public health . Contamination can lead to product recalls, damage brand reputation, and, in severe cases, cause serious health consequences or even death .
This article aims to explain the importance of reliable food microbiology testing in protecting both brands and consumers. By implementing thorough testing protocols, businesses can ensure compliance with safety regulations and prevent the distribution of contaminated products . FOSS provides food microbiology testing solutions that help companies maintain high standards of food safety and quality.
Why Food Microbiology Testing is Crucial
Food microbiology testing is a vital step in food production for several reasons.
Preventing Foodborne Illnesses and Protecting Public Health
One of the main reasons for food microbiology testing is to prevent foodborne illnesses. Harmful bacteria, viruses, and fungi can contaminate food products, leading to sickness, hospitalization, and even death. Regular testing identifies these hazards, allowing manufacturers to take corrective actions and protect public health .
Complying with Food Safety Regulations
Food safety regulations are in place to protect consumers and ensure that food products meet certain safety standards. Food microbiology testing helps companies comply with these regulations, avoiding potential fines, penalties, and legal repercussions . Compliance also demonstrates a commitment to safety, which can improve a company's reputation.
Protecting Brand Reputation and Consumer Trust
A company's brand reputation is one of its most valuable assets. Food recalls due to microbiological contamination can severely damage a brand's image and erode consumer trust. For example, a well-known chocolate brand had to recall millions of products due to Salmonella contamination, resulting in significant financial losses and a decline in consumer confidence. Taking action with food microbiology testing can prevent these incidents, safeguarding brand reputation and maintaining consumer trust .
Maintaining Product Quality and Shelf Life
Microorganisms can cause food spoilage, reducing product quality and shelf life. Testing helps identify spoilage organisms, allowing manufacturers to implement strategies to control their growth. This ensures that products remain fresh and safe for consumption for as long as possible .
Food microbiology testing is not just a regulatory requirement; it is a business imperative. It protects public health, ensures regulatory compliance, safeguards brand reputation, and maintains product quality.
Preventing Foodborne Illnesses and Protecting Public Health
Food microbiology testing directly contributes to the prevention of foodborne illnesses. Foodborne diseases affect millions of people each year, causing a range of symptoms from mild discomfort to severe, life-threatening conditions . According to the Centers for Disease Control and Prevention (CDC), foodborne diseases cause an estimated 48 million illnesses, 128,000 hospitalizations, and 3,000 deaths in the United States annually .
Food microbiology testing identifies and eliminates harmful pathogens before they can cause illness. Common pathogens tested for include Salmonella, Escherichia coli (E. coli), Listeria monocytogenes, and Campylobacter. Salmonella can cause salmonellosis, a common foodborne illness with symptoms such as diarrhea, fever, and abdominal cramps . E. coli, particularly certain strains like E. coli O157:H7, can lead to severe bloody diarrhea and kidney failure . Listeria monocytogenes can cause listeriosis, a serious infection that is especially dangerous for pregnant women, newborns, and individuals with weakened immune systems . Campylobacter is a common cause of diarrheal illness .
By detecting these pathogens early, food manufacturers can implement control measures such as improved sanitation practices, proper cooking procedures, and effective preservation techniques. These actions reduce the risk of contaminated products reaching consumers, safeguarding public health.
Complying with Regulations and Avoiding Legal Repercussions
The food industry operates under a strict regulatory environment designed to ensure food safety and protect public health. Compliance with these regulations is a legal requirement and a crucial aspect of responsible business practice.
Key food safety regulations and standards include the Food Safety Modernization Act (FSMA) in the United States and the Hazard Analysis and Critical Control Points (HACCP) system, which is used internationally . FSMA aims to prevent foodborne illnesses by shifting the focus from responding to outbreaks to preventing them. HACCP is a systematic approach to identifying and controlling hazards that could cause foodborne illness .
Food microbiology testing helps food producers meet these requirements by providing data to verify that their control measures are effective. Regular testing can identify potential hazards and ensure that products meet the required safety standards. Failure to comply with food safety regulations can result in significant penalties, fines, and legal action. For example, a dairy company was fined heavily after a Listeria outbreak linked to their cheese products resulted in multiple illnesses and deaths . Inadequate testing was cited as a contributing factor in the outbreak.
Documentation and traceability are vital in demonstrating compliance. Accurate records of testing procedures, results, and corrective actions provide evidence that a company is meeting its regulatory obligations. This documentation can be crucial in the event of an inspection or legal inquiry .
Protecting Brand Reputation and Consumer Trust
Food safety incidents can significantly impact brand reputation and consumer trust. A single recall or outbreak can damage a brand's image, eroding consumer confidence and leading to decreased sales. Consumers are more likely to trust brands that prioritize food safety and demonstrate a commitment to quality .
Food microbiology testing plays a vital role in building and maintaining a positive brand reputation. By implementing thorough testing protocols, companies can prevent food safety incidents and demonstrate their dedication to providing safe products. Regular testing can also help companies identify and address potential hazards before they escalate into larger problems .
Some companies have successfully used food safety to improve their brand image. For example, a poultry producer implemented advanced testing methods to reduce Salmonella contamination in their products. This commitment to safety was communicated to consumers through marketing campaigns, which increased brand loyalty and sales .
Transparency and communication are key in building trust with consumers. Companies that openly share information about their food safety practices are more likely to gain consumer confidence. Providing clear and accessible information about testing procedures, results, and corrective actions can demonstrate a commitment to safety and build trust with consumers .
Types of Food Microbiology Tests
Various food microbiology tests are available to detect and identify microorganisms in food products. These tests are categorized based on the type of microorganism they detect, including bacteria, viruses, fungi, and parasites .
Testing Methods
- Culture-Based Methods: These traditional methods involve growing microorganisms in a specific medium to identify and quantify them. Culture-based methods are reliable but can be time-consuming, often requiring several days for results .
- PCR (Polymerase Chain Reaction): PCR is a molecular technique that amplifies specific DNA sequences, allowing for rapid and sensitive detection of microorganisms. PCR is faster than culture-based methods but requires specialized equipment and expertise .
- ELISA (Enzyme-Linked Immunosorbent Assay): ELISA is an immunological method that uses antibodies to detect specific microorganisms or their toxins. ELISA is relatively quick and easy to perform but may not be as sensitive as PCR .
- Rapid Tests: These tests provide quick results, often within minutes or hours. Rapid tests are convenient for on-site testing but may not be as accurate as other methods .
Examples of specific tests for common foodborne pathogens include:
- Salmonella: Culture-based methods, PCR, and ELISA are commonly used to detect Salmonella in food products .
- E. coli: Culture-based methods, PCR, and rapid tests are used to detect E. coli, including the pathogenic strain E. coli O157:H7 .
- Listeria: Culture-based methods and PCR are used to detect Listeria monocytogenes .
Selecting the appropriate food microbiology testing method depends on the specific food product and potential hazards. Factors that should be considered include the type of microorganism being tested for, the required level of sensitivity, and the desired turnaround time for results .
Culture-Based Methods
Culture-based methods are a foundational aspect of food microbiology testing. These methods involve growing microorganisms in a controlled environment to identify and quantify them. The process typically includes sample preparation, incubation, and identification .
Process of Culturing Microorganisms
- Sample Preparation: The food sample is prepared by diluting it in a sterile solution. This helps to separate individual microorganisms and ensure accurate results .
- Incubation: The diluted sample is then placed in a specific growth medium, such as agar, which provides the necessary nutrients for microorganisms to grow. The medium is incubated at a specific temperature and for a specific period of time to allow the microorganisms to multiply .
- Identification: After incubation, the colonies of microorganisms that have grown on the medium are examined. Different types of microorganisms form colonies with distinct characteristics, such as size, shape, color, and texture. These characteristics are used to identify the microorganisms present in the sample .
Advantages and Disadvantages
Culture-based methods have several advantages. They can detect viable microorganisms, meaning they can distinguish between living and dead cells. They are also relatively low in cost compared to other testing methods .
However, culture-based methods also have disadvantages. They can be time-consuming, often requiring several days for results. This can delay the release of food products to the market. Also, culture-based methods can produce false negatives if the microorganisms are present in low numbers or if they are difficult to grow in the laboratory .
Examples of Specific Tests
Specific culture-based tests are used for detecting common foodborne pathogens. For example, Salmonella is often detected using selective agars that inhibit the growth of other microorganisms while allowing Salmonella to grow. Similarly, E. coli O157:H7 is detected using specific agars that produce a characteristic color change when the bacteria are present . Listeria monocytogenes is detected using enrichment broths followed by plating on selective agars .
Molecular Methods (PCR, qPCR)
Molecular methods, such as PCR (Polymerase Chain Reaction) and qPCR (quantitative PCR), play a significant role in modern food microbiology testing. These techniques detect specific DNA or RNA sequences of microorganisms, providing rapid and sensitive results .
How PCR and qPCR Work
PCR amplifies specific DNA sequences, creating millions of copies of a target sequence. This amplification allows for the detection of even small amounts of a microorganism's DNA. qPCR, also known as real-time PCR, measures the amount of DNA as it is being amplified, providing quantitative data on the number of microorganisms present in the sample .
Advantages and Disadvantages
PCR-based methods offer several advantages. They are highly sensitive, meaning they can detect even low levels of microorganisms. They are also highly specific, targeting unique DNA sequences to accurately identify specific pathogens. PCR methods are also faster than traditional culture-based methods, providing results in a matter of hours .
However, PCR methods also have disadvantages. They can detect non-viable microorganisms, meaning they may detect DNA from dead cells, which could lead to false positives. PCR methods are also more expensive than culture-based methods, requiring specialized equipment and reagents .
Examples of PCR Applications
PCR is used to detect pathogens like Salmonella, E. coli, and Listeria. For example, PCR assays can quickly identify the presence of Salmonella DNA in food samples, allowing for swift action to prevent contamination. Similarly, PCR can detect specific virulence genes in E. coli strains, helping to differentiate between harmless and harmful strains . qPCR can quantify the amount of Listeria monocytogenes in a sample, providing valuable information for risk assessment .
Immunoassay-Based Methods (ELISA)
Immunoassay-based methods, such as ELISA (Enzyme-Linked Immunosorbent Assay), are used in food microbiology testing to detect specific antigens (proteins) of microorganisms. These methods provide rapid results and are relatively easy to use .
How ELISA Works
ELISA uses antibodies that bind to specific antigens of microorganisms. The antibodies are attached to an enzyme that produces a color change when the antigen is present. The intensity of the color change is proportional to the amount of antigen in the sample, allowing for quantification of the target microorganism or toxin .
Advantages and Disadvantages
ELISA offers several advantages. It has a relatively high throughput, meaning many samples can be tested simultaneously. ELISA is also easy to use, requiring minimal training and equipment .
However, ELISA also has disadvantages. It has the potential for cross-reactivity, meaning the antibodies may bind to antigens from other microorganisms, leading to false positives. ELISA also has lower sensitivity compared to PCR, meaning it may not detect low levels of microorganisms .
Examples of ELISA Applications
ELISA is used to detect toxins or pathogens in food samples. For example, ELISA can detect toxins produced by Staphylococcus aureus, a common cause of food poisoning . It can also detect the presence of Salmonella antigens in egg products . ELISA kits are available for the detection of various foodborne pathogens, providing rapid results for food microbiology testing .
Rapid Tests and Emerging Technologies
Rapid tests and emerging technologies are transforming food microbiology testing by providing faster, more accurate, and more comprehensive results. These advancements allow for quicker decision-making and improved food safety .
Principles and Advantages
Rapid tests are designed to provide results in minutes or hours, compared to the days required for traditional culture-based methods. They are often easy to use, requiring minimal training and equipment. Emerging technologies offer increased sensitivity, specificity, and the ability to detect a wide range of microorganisms simultaneously .
Examples of Rapid Tests
- Lateral Flow Assays: These tests use antibodies to detect specific antigens, providing results in minutes. Lateral flow assays are commonly used to detect pathogens like Salmonella and E. coli .
- ATP Bioluminescence Assays: These tests measure the amount of adenosine triphosphate (ATP), a molecule found in all living cells. ATP bioluminescence assays can quickly assess the overall microbial load in a food sample .
Emerging Technologies
- Sequencing (NGS): NGS allows for the rapid sequencing of DNA or RNA, providing comprehensive information about the microorganisms present in a sample. NGS can identify all microorganisms in a sample, including bacteria, viruses, and fungi, and can also provide information about their virulence and antibiotic resistance .
- Biosensors: Biosensors use biological molecules, such as enzymes or antibodies, to detect specific microorganisms or toxins. Biosensors can provide real-time monitoring of food samples, allowing for early detection of contamination .
These technologies have the potential to significantly improve food microbiology testing by providing faster, more accurate, and more comprehensive results. This leads to improved food safety and reduced risk of foodborne illnesses .
Benefits of Choosing a Reliable Testing Partner
Partnering with a reputable and experienced food microbiology testing provider offers numerous benefits. These include accurate results, fast turnaround times, expert guidance, comprehensive testing services, regulatory compliance, and traceability .
- Accurate and Reliable Results: A reliable testing partner uses validated methods and quality control procedures to ensure the accuracy and reliability of results. This minimizes the risk of false positives or negatives, providing confidence in the safety of food products .
- Fast Turnaround Times: A testing partner with efficient processes and advanced technology can provide results quickly, allowing for faster decision-making and reduced time-to-market .
- Expert Interpretation of Results and Guidance: Experienced microbiologists can interpret test results and provide guidance on corrective actions, helping food producers address potential hazards and improve their food safety programs .
- Comprehensive Testing Services: A reliable partner offers a wide range of testing services, covering various microorganisms and food matrices. This ensures that all potential hazards are identified and controlled .
- Compliance with Industry Standards and Regulations: A reputable testing provider is familiar with industry standards and regulations, helping food producers meet their compliance obligations and avoid legal repercussions .
- Traceability and Data Management: A testing partner with effective data management systems can provide traceability of samples and results, which is vital for demonstrating compliance and managing food safety risks .
FOSS offers advanced food microbiology testing solutions and can be a reliable partner in assuring food safety. Their expertise and technology help companies maintain high standards of quality and compliance.
Assuring Accurate and Reliable Results
Accurate and reliable results are crucial in food microbiology testing. These results inform critical decisions about food safety, production processes, and regulatory compliance. A reliable testing partner assures the accuracy of results through validated methods, quality control procedures, and experienced personnel .
Validated methods are testing procedures that have been scientifically proven to provide accurate and reproducible results. Quality control procedures involve monitoring the testing process to identify and correct any errors or inconsistencies. Experienced personnel are trained to perform tests accurately and interpret results correctly .
Inaccurate results can have serious consequences. False positives can lead to unnecessary product recalls and financial losses. False negatives can result in contaminated products reaching consumers, causing foodborne illnesses and damaging brand reputation .
A reliable partner minimizes these risks through rigorous testing protocols and data analysis. They use validated methods, implement quality control procedures, and employ experienced personnel to ensure the accuracy and reliability of results. FOSS is committed to accuracy in food microbiology testing, providing customers with the confidence they need to make informed decisions about food safety.
Achieving Fast Turnaround Times
Fast turnaround times are vital in food microbiology testing, especially in time-sensitive situations. Delays in receiving test results can lead to slower product release, increased storage costs, and delayed responses to potential contamination issues .
A reliable testing partner optimizes its processes to deliver results quickly without compromising accuracy. This involves using advanced technology, streamlining workflows, and employing skilled personnel. They understand the importance of providing timely information to help food producers make informed decisions .
Fast turnaround times offer several benefits. They allow for faster release of products, reducing storage costs and improving efficiency. They also enable quicker response to potential contamination issues, minimizing the risk of foodborne illnesses and product recalls .
For example, a food producer experiencing a potential contamination issue can use fast turnaround times to quickly identify the source of the contamination and implement corrective actions. This can prevent the spread of contamination and protect consumers. FOSS prioritizes efficiency in food microbiology testing to meet the needs of its clients, providing fast turnaround times without sacrificing accuracy.
Gaining Expert Interpretation and Guidance
Expert interpretation of food microbiology testing results is invaluable. Raw data alone is not always enough to make informed decisions about food safety. A reliable testing partner provides expert guidance on interpreting results, identifying potential risks, and implementing corrective actions .
Having access to experienced microbiologists and food safety professionals is important. They can provide insights and recommendations based on their knowledge and expertise. They can also help food producers understand the implications of test results and develop effective strategies to address any issues .
Expert guidance can help food producers make informed decisions and action with food safety challenges. For example, an experienced microbiologist can identify the source of a contamination issue and recommend specific sanitation practices to prevent recurrence. They can also help food producers develop and implement food safety plans that comply with regulatory requirements .
FOSS offers expert support and consultation as part of its food microbiology testing services. Their team of experienced professionals can provide the guidance and support needed to ensure food safety and compliance.
Comprehensive Testing Services and Compliance
Choosing a testing partner that offers comprehensive testing services is beneficial. These services should cover a wide range of microorganisms and food matrices. This comprehensive approach ensures that all potential hazards are identified and addressed, minimizing the risk of foodborne illnesses and product recalls .
Compliance with industry standards and regulations is also important. A reliable testing partner should be accredited to ISO 17025, which demonstrates their competence to carry out testing and calibration services . Compliance with regulations helps food producers meet regulatory requirements and maintain a safe food supply.
A reliable testing partner helps food producers meet regulatory requirements by providing accurate and reliable test results, expert guidance on interpreting results, and support in developing and implementing food safety plans. They also stay up-to-date on the latest regulatory changes and provide guidance on how to comply with these changes .
FOSS provides a full suite of food microbiology testing solutions to ensure compliance and comprehensive coverage. Their services help food producers meet regulatory requirements and maintain a safe food supply.
Conclusion: Assuring a Safer Food Supply Through Microbiology Testing

Food microbiology testing is vital for assuring food safety, protecting public health, and maintaining brand reputation. Throughout this article, we have discussed the importance of testing, the types of tests available, and the benefits of choosing a reliable testing partner.
Investing in reliable food microbiology testing services is important. It helps to prevent foodborne illnesses, comply with regulations, protect brand reputation, and maintain product quality. By implementing thorough testing protocols, businesses can ensure that their products are safe for consumption and meet the highest standards of quality.
Prioritize food safety and consider partnering with FOSS for your testing needs. FOSS offers advanced food microbiology testing solutions, expert support, and a commitment to accuracy and reliability. Contact FOSS today to learn more or request a consultation and take the next step in assuring the safety of your food products.
Frequently Asked Questions
- What types of microbiology tests are essential for food safety?
- Essential microbiology tests for food safety typically include testing for pathogens such as Salmonella, E. coli, Listeria, and Campylobacter. Additionally, tests for total aerobic plate count, yeast and mold counts, and specific spoilage organisms are important to assess overall microbial quality. These tests help identify harmful bacteria and ensure that food products meet safety standards.
- How often should food products be tested for microbiological safety?
- The frequency of microbiological testing depends on various factors, including the type of food product, the production process, and regulatory requirements. Generally, high-risk foods should be tested more frequently, potentially every batch or lot, while lower-risk items may require testing on a less regular basis. It's crucial to establish a testing schedule that aligns with industry standards and specific business needs.
- What are the benefits of using a third-party microbiology testing service?
- Using a third-party microbiology testing service offers several benefits, including impartiality, expertise, and advanced testing technologies. It allows food manufacturers to ensure compliance with regulatory standards without bias, while also providing access to specialized knowledge and resources that may not be available in-house. This can enhance product safety, improve quality assurance processes, and build consumer trust.
- How can food companies implement a microbiological testing program effectively?
- To implement an effective microbiological testing program, food companies should start by conducting a risk assessment to identify potential hazards. Next, they should develop a comprehensive testing plan that outlines what to test, how often to test, and which testing methods to use. Training staff on proper sampling techniques and maintaining accurate records are also essential. Finally, regularly reviewing and updating the program based on test results and industry developments will help ensure ongoing food safety.
- What regulations govern microbiology testing in the food industry?
- Regulations governing microbiology testing in the food industry vary by country but often include guidelines set by government agencies such as the FDA in the United States or the EFSA in Europe. These regulations outline acceptable levels of microbial contamination, testing methods, and record-keeping requirements. It is crucial for food businesses to stay informed about relevant regulations to ensure compliance and avoid potential legal issues.




